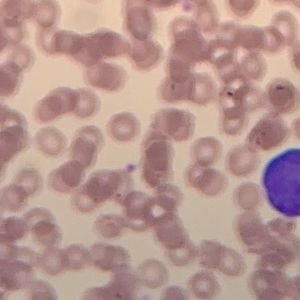

SOLD! 1 Month Membership to XvsNcXVV_KDDtYxFESOLD! 1 Month Membership to Blubaby27SOLD! 12 Month Membership to RotHrcwN_fplDZwbCSOLD! 1 Month Membership to Flan1234SOLD! 1 Month Membership to nhbspsSOLD! 12 Month Membership to anuDEraN_CgxXHQBISOLD! 1 Month Membership to brillturned3SOLD! 1 Month Membership to marudolph5376SOLD! 1 Month Membership to QHMhiZyB_acMYSJWrSOLD! 1 Month Membership to gerbeniSOLD! 1 Month Membership to XvsNcXVV_KDDtYxFESOLD! 1 Month Membership to Blubaby27SOLD! 12 Month Membership to RotHrcwN_fplDZwbCSOLD! 1 Month Membership to Flan1234SOLD! 1 Month Membership to nhbspsSOLD! 12 Month Membership to anuDEraN_CgxXHQBISOLD! 1 Month Membership to brillturned3SOLD! 1 Month Membership to marudolph5376SOLD! 1 Month Membership to QHMhiZyB_acMYSJWrSOLD! 1 Month Membership to gerbeni